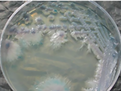
熱帶假絲酵母

熱帶假絲酵母 熱帶假絲酵母,屬殼霉目,杯霉科,拉丁名為Candida tropicalis。
基本信息 簡介 熱帶假絲酵母(Candida tropicalis)即熱帶念珠菌 生存環境 熱帶念珠菌是一種腐物寄生菌,廣泛存在於自然界,可從水果、蔬菜、乳製品、土壤中分離出。也可存在於健康人體的皮膚、陰道、口腔和消化道等部位。約10%的健康婦女和30%的孕婦可無任何臨床症狀而陰道內帶有念珠菌。當機體抵抗力降低或陰道局部環境發生改變時,熱帶念珠菌就大量繁殖,產生病變。所以,熱帶念珠菌是一種條件致病菌。 10%~20%非孕婦女及30%孕婦陰道中有此菌寄生但菌量極少鵻,呈酵母相,並不引起症狀。熱帶念珠菌生長最適宜的pH值為5.5,陰道的弱酸性環境能保持陰道的自潔功能,正常人為3.7-4.5,但陰道的弱酸性改變為pH5.5後,熱帶念珠菌大量繁殖,並轉變為菌絲相鵻,才引發陰道炎症狀。因此用Ph4弱酸配方的女性護理液除了適合日常的清潔保養外,治病期間使用嬌妍弱酸配方的女性護理液對黴菌的生長繁殖會有抑制作用。在生物系統中位置 真菌界 半知菌亞門 芽孢菌綱 隱球酵母目 隱球酵母科 念珠菌屬 熱帶念珠菌形態 是一種雙相型單細胞酵母菌,熱帶念珠菌(C.tropicalis)是生殖器念珠菌病的第二病原菌。為芽生,有假菌絲,有厚壁孢子、無子囊。一般情況下呈卵圓形 的單壁細胞。大小為2μm X 6μm,成群分布,尚可見分隔的假菌絲,革蘭染色陽性。熱帶念珠菌在人體中可見到不同期表現,無症狀時為酵母型,呈圓形或橢圓形;在侵犯黏膜組織致病時,常表現為菌絲型,為長條型的假菌絲。熱帶念珠菌檢查 念珠菌顯色培養基根據酶底物法,通過顯色來區別不同念珠菌,25-28℃培養48小時後,白色念球菌藍綠色,熱帶念珠菌顯藍灰色或鐵藍色,光滑念珠菌顯紫色,克柔假絲酵母顯粉色,其它念珠菌顯白色,細菌被抑制。 用法 稱取本品9.6g(可按4.8g/100ml的比例擴大或縮小),加入200ml蒸餾水或純化水中,加熱溶解並不停攪拌,煮沸不要超過1分鐘。將加熱後的培養基水浴冷卻至45-50℃,輕輕地搖勻,傾入無菌平皿(9cm的15ml/皿,7cm的10ml/皿),瓊脂完全凝固後,在36℃±1℃的培養箱中倒置放置0.5-1小時,備用。 操作步驟 1、按國家標準、SN標準、FDA標準或其它方法製備樣品液; 2、取樣品液塗布或劃線接種於平板上; 3、25-28℃培養48h。白色念珠菌典型特徵為藍綠色,熱帶念珠菌顯藍灰色或鐵藍色,光滑念珠菌顯紫色,克柔假絲酵母顯粉色,其它念珠菌顯白色,細菌被抑制。 4 、對可疑白色念珠菌菌落可劃線接種到PDA瓊脂平板上,25-28℃培養24-48小時,挑取單菌落做鏡檢和生化試驗。培養 在葡萄糖—酵母汁—蛋白腖液體培養基中培養,25℃,3天,細胞呈球形或卵球,其中大小為4~8×6~11µm。在麥芽汁瓊脂上菌落為白色到奶油色,無光澤或稍有光澤。軟而平滑或部分有皺紋。培養時間長時,菌落變硬。在加蓋玻片的玉米粉瓊脂培養基上培養,可看到大量的假菌絲和芽生孢子。 快速鑑定光滑念珠菌與熱帶念珠菌的方法 以傳統發酵法檢測光滑念珠菌、白念珠菌、熱帶念珠菌發酵海藻糖情況。採用4%海藻糖液孵育各試驗株3小時後用尿糖試紙檢測。E-test法測試光滑念珠菌對氟康唑、伊曲康唑的敏感性。結果:光滑念珠菌與熱帶念珠菌皆可發酵海藻糖,尿糖試紙呈陽性反應,但後者菌落在科瑪嘉色原培基為藍色,在米粉吐溫瓊脂有假菌絲。結論:採用海藻糖法配合米粉吐溫瓊脂或科瑪嘉色原培養基可以快速簡便鑑定光滑念珠菌和熱帶念珠菌。臨床分離的真菌構成情況和變化趨勢 北京協和醫院1999~2005年臨床分離的真菌仍以白念珠菌所占比例最大,其次熱帶念珠菌和光滑念珠菌,近年來麴黴菌所占比例有所增高,臨床真菌送檢量及陽性檢出率都明顯升高。 不同標本來源分離的菌株分布不同:血液標本中所占比例最多的分別是白念珠菌、熱帶念珠菌和近平滑念珠菌;腦脊液標本中新生隱球菌所占比例最多,其次白念珠菌和熱帶念珠菌;肺泡灌洗液中白念珠菌最多,其次青黴、煙麴黴、光滑念珠菌;尿液、生殖道分離的菌株白念珠菌最多,其次為光滑念珠菌和熱帶念珠菌;呼吸道分離的白念珠菌最多,其次為熱帶念珠菌和光滑念珠菌。 血源念珠菌感染與手術治療,中心靜脈插管等有一定的相關性。 北京協和醫院ICU病房在2004和2005年存在白念珠菌和熱帶念珠菌的克隆流行;同一患者不同標本來源或不同時間採集標本白念珠菌無明顯克隆流行性,熱帶念珠菌有明顯的克隆流行性。唐山市人民醫院分離的白念珠菌存在明顯的克隆流行性,熱帶念珠菌也有一定的克隆流行性。熱帶念珠菌和白色念珠菌毒力差異 熱帶念珠菌(C.t)和白色念珠菌(C.a)是引起全身性念珠菌感染的主要致病原。曾有報導,C.t的致病性比C.a強,也有報導念珠菌對人肺上皮細胞的粘附是一種特異性的粘附 ,臨床標本來源的白色念珠菌粘附宿主細胞的能力比熱帶念珠菌強。念珠菌的致病力與菌體形態和黏附能力有關,酵母型一般不致病,菌絲型有致病性。黏附力強的念珠菌致病力亦強。 熱帶念珠菌和白色念珠菌毒力差異沒有定論。熱帶念珠菌病 綜述 念珠菌病主要是白色念珠菌引起的急性、亞急性或慢性感染,是最常見的真菌病。常侵犯皮膚、黏膜,也可引起內臟或全身感染。臨床症狀錯綜複雜,急緩不一。兒童多為急性繼發性感染。近年來隨著大劑量抗生素、激素、免疫抑制劑的套用,以及器官移植術的開展,其發病率漸趨增高,並可危及生命造成嚴重後果。 生殖器念珠菌病分為念珠菌性陰道炎和念珠菌性龜頭炎。兩者與性行為關係密切,可以通過性行為互相傳播。 念珠菌性陰道炎(candidal vaginitis),又稱外陰陰道念珠菌病(vulvovaginal candidiasis, VVC),是由陰道內的念珠菌,主要為白色念珠菌引起的陰道及外陰的炎症性疾病。 臨床以典型的豆腐渣樣白帶及劇烈的外陰瘙癢為特徵。急性發作的病人如果治療不徹底則容易轉為慢性復發性念珠菌性陰道炎(RVVC )。 念珠菌性龜頭炎是念珠菌引起的男性包皮龜頭的炎症。臨床症狀 (一)皮膚念珠菌病 1.指(趾)間糜爛多見於長期從事潮濕作業的人。皮疹以第三、第四指(趾)間最為常見。指(趾)間皮膚浸漬發白,去除浸漬的表皮,呈界限清楚的濕潤面,基底潮紅,可有少量滲液。自覺微癢或疼痛感。 2.念珠菌性間擦疹多見於小兒和肥胖多汗者。皮疹好發於腹股溝、臀溝、腋窩及乳房下等皺褶部位。局部有界限清楚的濕潤的糜爛面,基底潮紅,邊緣附領口狀鱗屑。外周常有散在紅色丘疹、皰疹或膿皰。 3.丘疹形念珠菌病多見於肥胖兒童,可與紅痱並發。皮疹為綠豆大小扁平暗紅色丘疹,邊緣清楚,上覆灰白色領圈狀鱗屑,散在或密集分布於胸背、臀或會陰部。同時伴發念珠菌性口角炎、口腔炎。 4.念珠菌性甲溝炎、甲床炎多見於指甲。甲溝紅腫,或有少量溢液,但不化膿,稍有疼痛和壓痛,病程慢性。甲板混濁,有白斑,變硬,表面有橫嵴和溝紋,高低不平但仍有光澤,且不破碎。 5.慢性皮膚黏膜念珠菌病少見。是一種慢性進行性的念珠菌感染,常伴有某些免疫缺陷或內分泌疾患,如甲狀旁腺、腎上腺功能低下等,特別是先天性胸腺瘤。本病常是從嬰兒期開始發病,但也可發生於新生兒期。皮損好發生於頭面部、手背及四肢遠端,偶見於軀幹。初起為紅斑、丘疹鱗屑性損害,漸呈疣狀或結節狀,上覆黃褐色或黑褐色蠣殼樣痂皮,周圍有暗紅色暈。有的損害高度增生,呈圓錐形或楔形,形似皮角,去掉角質塊,其下是肉芽腫組織。愈後結痂,累及頭皮的可致脫髮。 (二)黏膜念珠菌病 1.鵝口瘡多見於嬰幼兒患者,口腔黏膜、咽、舌、牙齦等處出現邊界清楚的白色假膜,外圍紅暈。去除假膜可見紅色濕潤基底。若累及口角則有口角糜爛、皸裂等,有疼痛感。 2.生殖器念珠菌病包括女陰陰道炎及龜頭包皮炎。臨床症狀陰道黏膜發紅、水腫 ,有白色 凝乳狀或片塊狀膜樣物附著,易剝離,其下可有糜爛或淺潰瘍,白帶很多,呈水樣或膿樣,其中有大小不等的乳酪樣白色塊狀物或豆腐渣樣物。 (三)內臟念珠菌病 念珠菌感染可累及全身所有內臟器官,其中以腸念珠菌病及肺念珠菌病較常見。此外,尚可引起泌尿道炎、腎孟腎炎、心內膜炎及腦膜炎等,偶可引起念珠菌性敗血症。所有內臟感染常繼發於多種慢性消耗性疾病,且有長期套用廣譜抗生素、皮質激素及化療、放療等誘發因素,症狀多無特異性,應提高警惕。 (四)念珠菌疹 為念珠菌及其代謝產物引起的皮膚變態反應,主要損害為成群的無菌性水皰,多見於手指間;也可見到銀屑病樣、玫瑰糠疹樣、脂溢性皮炎樣、蕁麻疹樣、離心性環狀紅斑樣損害。生殖器念珠菌病的治療 一般治療 治療假絲酵母菌感染首先應消除誘因:若有糖尿病應給予積極治療。及時停用廣譜抗生素、雌激素及皮質類固醇激素。 積極治療可以消除易感因素。每天用嬌妍清洗外陰,養成良好的衛生習慣,Ph4弱酸配方的女性護理液適合日常的清潔保養,並保持外陰乾燥,避免搔抓。不宜食用辛辣刺激性食品,效果很好。勤換內褲,並用溫水進行洗滌,切不可與其他衣物混合洗,避免交叉感染。 改變陰道酸鹼度 念珠菌生長最適宜的pH值為5.5,陰道的弱酸性環境能保持陰道的自潔功能,正常人為3.7-4.5,因此用Ph4弱酸配方的女性護理液除了適合日常的清潔保養外,治病期間使用弱酸配方的女性護理液對黴菌的生長繁殖會有抑制作用。外出如廁時要用嬌妍女性衛生濕巾拭乾外陰,保持外陰乾燥,以抑制念珠菌的生長。 外陰洗液 使用一些外陰外陰洗液,如嬌妍潔陰洗液。每晚上藥洗一次。 藥物療法 假絲酵母菌外陰陰道炎的治療有局部用藥、全身用藥及聯合用藥(口服加局部)等。選擇局部或全身套用抗真菌藥物;根據患者的臨床分類,決定療程的長短。 單純性VVC 的治療:局部用藥可選擇下列藥物放於陰道內:①咪康唑栓劑,每晚1 粒(200mg),連用7 天;或每晚1 粒(400mg),連用3 天;②克霉唑栓劑,每晚1 粒(150mg),塞入陰道深部,連用7 天,或每天早、晚各1 粒(150mg),連用3 天;或1 粒(500mg),單次用藥;③嬌妍凝膠消毒劑,每晚一次,連用10~14 天。 單純性VVC 也可選擇口服藥物:氟康唑150mg,頓服。也可選用伊曲康唑每次200mg,1 次/d,連用3~5 天;或用1 天療法,口服400mg,分2 次服用。一般用藥後2~3天症狀減輕或消失,有效率80%~90%。 最早用於治療酵母菌感染的特異性活性藥物是多黴菌素,它是20世紀50年代早期分離獲得的一種聚烯類抗生素,此後又有許多種抗真菌藥物被研製出來。陰道假絲酵母菌病的臨床用藥,多數為局部用藥,近年高效短療程的口服製劑問世,更使患者易於接受,且適用於經期及未婚女性。陰道假絲酵母菌病藥物治療中要求性伴侶作生殖器真菌培養及適當抗真菌治療,應同時用藥。治療中症狀消失後,須每次月經後複查並鞏固治療1個療程。念珠菌陰道炎的危害 1、造成不孕 如果患了念珠菌性陰道炎,陰道的酸鹼度的改變會使精子的活動力受到抑制,且炎性細胞可吞噬精子,並使精子活動力減弱,白色念珠菌有凝集精子的作用,以及炎症發生時的性交痛和性慾減退等,均可影響懷孕。此種不孕經積極治療後可很快恢復正常。但念珠菌性陰道炎導致的不孕是暫時性的,疾病治癒後仍可受孕。 2、影響胎兒發育 孕婦患病後,極少數人陰道中的念珠菌能經宮頸上行,穿透胎膜感染胎兒,引起早產。另外,當胎兒經母親陰道分娩時,也可能被念珠菌感染,多引起口腔念珠菌病,如通常所說的鵝口瘡就是口腔念珠菌感染引起的。有些嬰兒還可能出現肛門周圍念珠菌性皮炎。由此可見,為了避免感染胎兒,孕婦患念珠菌性陰道炎後應積極治療。 3、影響生活質量 得了念珠菌性陰道炎,會伴有外陰瘙癢等症狀,對女性的生活和工作會造成諸多的不便和影響,也會影響到夫妻生活。 4、引起其他疾病 若念珠菌性陰道炎長期不治療的話,易造成炎症上行,引起宮頸炎和宮頸糜爛,如果病原體進入宮腔,則會引起輸卵管卵巢炎症、盆腔炎等,最後影響懷孕。